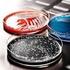
Antibiotikaresistenz: Carbapenemase-bildende Keime in Nutztierbeständen

Birnenverfall - Eine Einführung
|
|
|
- Chantal Hermann
- vor 8 Jahren
- Abrufe
Transkript
1 Birnenverfall Eine Einführung Dr. Wolfgang Jarausch AlPlantaIPR, Neustadt a.d.weinstraße, Deutschland Foto: J. Egger (Birneverfall (Schweizer Wasserbirne)
2 Birnenverfall Pear Decline bakterielle Krankheit der Birne (Phytoplasmose) hohe Schäden in der Vergangenheit in Nordamerika und Italien Ertragsausfall Absterben verstärkte Ausbreitung der Krankheit in Europa in den letzten Jahren: Erwerbsobstanbau Streuobstanbau
3 Historie Erstbeschreibung: in Europa: Mader, 1908 (moria del pero, Italien) in Nordamerika: McLarty, 1948 (British Columbia) Identifizierung des Erregers: Nachweis der Übertragbarkeit: Jensen et al., 1964 Nachweis eines MLOs: Hibino and Schneider, 1970 SpeziesKlassifizierung: Seemüller & Schneider, 2004 Pear tree cv. Abate Fetel grafted on quince BA29 affected by pear decline. Foto: EPPO
4 Wirtspflanzen verschiedenste Birnenarten: Pyrus spp. Kulturarten der Birne (Sorte, Unterlage) Nashi Wildarten Quitte: Cydonia spp. Unterlagensorten Birne Nashi Japanese pear (nashi) cv. Hosui showing enlarged vein with leaf curl induced by pear decline. Foto: EPPO
5 Schneller Verfall Quick decline Trockenstress anfällige Unterlage starke Wurzelschädigung Williams auf Kirchensaller (Foto Giunchedi)
6 Langsamer Verfall Slow decline langsames, progressives Absterben auf wenig toleranten Unterlagen Abate Fetel auf Quitte BA29 Conference auf Quitte A Fotos L. Giunchedi, Università degli Studi, Bologna
7 Symptome beim langsamen Verfall: Rotlaubigkeit auf toleranten Unterlagen: vorzeitige Rotlaubigkeit vorzeitiger Blattfall z.t. Blattrollen Reduktion in Wuchs, Ertrag und Fruchtgröße jährliche Schwankung der Symptomausprägung bis zum Verschwinden
8 Verbreitung der Krankheit Nordamerika Europa Vorderasien Taiwan: PDTW (pear decline Taiwan)
9 Pear Decline in Europe (COST action FA0807)
10 Der Erreger Zellwandloses, Pflanzenpathogenes Bakterium frühere Bezeichnung: Mycoplasmalike Organinsm (MLO) (entdeckt 1968) heute: Phytoplasma nicht kultivierbar nur in den Siebröhren (Phloem) der Pflanzen übertragen durch Phloemsaugende Insekten Candidatus Phytoplasma pyri
11 Der Erreger des Birnenverfalls ist eng verwandt mit anderen Obstphytoplasmen ESFY Ca. Phytoplasma prunorum Ca. Phytoplasma mali Europäische Steinobstvergilbung Apfeltriebsucht Ca. Phytoplasma pyri Phylogenetische Analyse des ribosomalen 16S rrna Gens AP
12 Phytoplasmen sind eine der kleinsten lebenden Organismen Escherichia coli 4.6 Mb Erwinia amylovora 4.5 Mb Ca. Phytoplasma asteris Mb Ca. Phytoplasma mali 0.65 Mb Mycoplasma genitalium 0.53 Mb Carsonella rudii 0.16 Mb Sequenziertes Genom von Ca. P. mali Kube et al., 2008 Phytoplasmen sind abhängig vom Wirt
13 Hohe genetische und biologische Variabilität Vermehrung in der Pflanze spezielle Bedingungen im Phloem Vermehrung im Insekt spezielle Bedingungen in der Hämolymphe Ca. Phytoplasma mali fehlen bestimmte genetische Reparaturmechanismen => ohne Selektionsdruck werden Mutanten akkumuliert
14 Molekularer Nachweis mittels PCR oder realtime PCR Nachweis in Pflanze und Insekt sensitivster Nachweis spezifischer Nachweis RoutineDiagnose PCR = PolymeraseKetteReaktion Bestimmung der Konzentration der Phytoplasmen mittels realtime PCR möglich
15 Entwicklung spezifischer PCRPrimer für die direkte Identifizierung von Ca. Phytoplasma pyri 16S rdna 23S rdna fu5 ru4 fo1 fpdb ro1 rpdw Nachweis von Ca. P. pyri mit verschiedenen PCR Primern universell für alle Phytoplasmen spezifisch für Obstphytoplasmen spezifisch für Ca. P. pyri spezifisch für Ca. P. pyri fu5/ru4 Ahrens & Seemüller, 1992 fo1/ro1 Lorenz et al., 1995 fpd/rpds Lorenz et al., 1995 fpdb/rpdw Etropolska et al., / 122 (100%) 118 / 122 (96,7%) 97 / 122 (79,5%) 110 / 122 (90,2%)
16 Nachweisbarkeit (%) Nachweisbarkeit von Ca. P. pyri im Jahresverlauf Wurzel Stamm Sproß II III IV V VI VII VIII IX X XI XII I II III IV V Monate Daten: E. Seemüller, JKI Dossenheim
17 Korrelation von Symptomen mit PCR Nachweis der Phytoplasmen Versuchsjahr Blattfärbung Anzahl Proben getestet Anzahl Proben PCR positiv % Proben PCR positiv 2010 leicht rötlich % rot % braunrötlich % gelb % 2012 rot % grün gelb % 2013/2014 rotlaubig % Es gibt kein sicheres Symptom!
18 Das Problem der unregelmäßigen Verteilung der Phytoplasmen im Baum Wurzel 20 Sproßproben in 5 cm Abständen Pflanze 1 Pflanze 2 Daten: Dr. Bernd Schneider, Julius KühnInstitut, Dossenheim, Deutschland Probenahme 20. Mai PDw ex vitro Pflanzen gleichen Alters. Primer fo1/ro1. Die Sicherheit des Nachweises ist abhängig von der Probennahme
19 Das Problem der Latenz Zeitraum zwischen Beginn der Infektion und erstem Auftreten von Symptomen abhängig von der Stärke des Inokulums Übertragung durch Insekt experimentelle Inokulation abhängig vom physiologischen Zustand des Baumes Alter des Baumes Widerstandsfähigkeit
20 Übertragungswege der Krankheit Phloemverbindungen: Pfropfung (experimentell oder durch latent infiziertes Reis) Wurzelverwachsungen (Hypothese) Phloemsaugende Insekten infiziertes, vegetativ vermehrtes Pflanzgut (z.b. Unterlagen) keine Übertragung durch Samen oder Pollen keine mechanische Übertragung (z.b. Schnittwerkzeuge)
21 Ausbreitung der Krankheit durch das Pflanzgut Ca. Phytoplasma pyri ist ein QuarantäneSchaderreger: Einschleppung und Ausbreitung in EU verboten Pflanzmaterial muss frei von Phytoplasmen sein Nachweis von Birnenverfall im Muttergarten oder in der Baumschule in der Praxis schwierig visuelle Bonitur nicht ausreichend molekularer Test nur stichprobenhaft möglich Ausbreitung der Krankheit durch infiziertes Pflanzmaterial über große Distanzen möglich hohes Risiko der Verbreitung durch nichtzertifizierte Vermehrung
22 Der Birnenverfall im Labor Ca. P. pyriinfizierte Birne in vitro Pfropf Übertragung in vitro gesunde Birne in vitro
23 Das Problem der biologischen und genetischen Variabilität des Erregers im Genom von Ca. Phytoplasma pyri wurden hochvariable Gene identifiziert z.b. imp, acef, pnp, secy (Danet et al., 2011) in der Pflanze existieren Populationen von genetischen Varianten biologische Bedeutung noch unklar (Bsp. virulente oder avirulente Stämme) welche Varianten durch Insekten übertragen werden können, ist nicht untersucht molekulare Marker für epidemiologische Studien?
24 Molekulare Varianten des Markers pnp PYRISpa1 100 P1 P2 Ca. P. prunorum PYRIAZPOI45 P6 P5 P4 P3 100 PYRISpa3 P7 P13 P12 P9 P10 P11 Ca. P. mali Ca. P. pyri P14 99 P15 PYRISpa2 Danet et al., nucleotides P8
25 Der Birnenverfall ist ein komplexes System Umwelt Pflanze Überträger Phytoplasma
26 Ansätze für Bekämpfungsmaßnahmen Umwelt Reduzierung des Schadens = resistente Unterlagen weniger anfällige Sorten Reduzierung des Inokulums = gesundes Pflanzmaterial Rodung kranker Bäume resistente Unterlagen Pflanze Überträger Phytoplasma Reduzierung der Überträger = effiziente Insektizidbehandlungen Entwicklung umweltschonender Bekämpfungsmethoden
Aktueller Stand der. Forschungen zum
 Aktueller Stand der MASTERTITELFORMAT Forschungen zum BEARBEITEN Birnenverfall in Formatvorlage des Untertitelmasters Österreich M. Riedle-Bauer, C. Paleskić, G. Brader, U. Persen --- 1 --- Symptomatik
Aktueller Stand der MASTERTITELFORMAT Forschungen zum BEARBEITEN Birnenverfall in Formatvorlage des Untertitelmasters Österreich M. Riedle-Bauer, C. Paleskić, G. Brader, U. Persen --- 1 --- Symptomatik
Abteilung: FIRMICUTES-Gram-positiv KLASSE: FIRMIBACTERIA-meist einzellige Bakterien Genera: Bacillus Clostridium
 BACTERIA Abteilung: GRACILICUTES-Gram-negativ KLASSE: PROTEOBACTERIA, einzellige Bakterien Family: Enterobacteriaceae Genus: Erwinia Familie: Pseudomonadaceae Genera: Ralstonia Pseudomonas Rhizobacter
BACTERIA Abteilung: GRACILICUTES-Gram-negativ KLASSE: PROTEOBACTERIA, einzellige Bakterien Family: Enterobacteriaceae Genus: Erwinia Familie: Pseudomonadaceae Genera: Ralstonia Pseudomonas Rhizobacter
 I. II. I. II. III. IV. I. II. III. I. II. III. IV. I. II. III. IV. V. I. II. III. IV. V. VI. I. II. I. II. III. I. II. I. II. I. II. I. II. III. I. II. III. IV. V. VI. VII. VIII.
I. II. I. II. III. IV. I. II. III. I. II. III. IV. I. II. III. IV. V. I. II. III. IV. V. VI. I. II. I. II. III. I. II. I. II. I. II. I. II. III. I. II. III. IV. V. VI. VII. VIII.
Schwarzbeinigkeit ein Problem im Kartoffelbau. Gerda Bauch Bayerische Landesanstalt für Landwirtschaft
 Schwarzbeinigkeit ein Problem im Kartoffelbau Gerda Bauch Bayerische Landesanstalt für Landwirtschaft Schäden durch Schwarzbeinigkeit Auflaufschäden Ertragsverluste Kümmerpflanzen Ertragsverluste Fäulnis
Schwarzbeinigkeit ein Problem im Kartoffelbau Gerda Bauch Bayerische Landesanstalt für Landwirtschaft Schäden durch Schwarzbeinigkeit Auflaufschäden Ertragsverluste Kümmerpflanzen Ertragsverluste Fäulnis
Austausch von gentechnisch veränderten Tieren zwischen experimentellen Tierhaltungen
 Austausch von gentechnisch veränderten Tieren zwischen experimentellen Tierhaltungen Werner Nicklas Detmold, 30. März 2012 Hygiene beschreibt ganz allgemein alle Maßnahmen, die zur Erhaltung der Gesundheit
Austausch von gentechnisch veränderten Tieren zwischen experimentellen Tierhaltungen Werner Nicklas Detmold, 30. März 2012 Hygiene beschreibt ganz allgemein alle Maßnahmen, die zur Erhaltung der Gesundheit
ESBL in Altenheimen: Ergebnisse einer LGL-Studie. Dr. Giuseppe Valenza
 ESBL in Altenheimen: Ergebnisse einer LGL-Studie Dr. Giuseppe Valenza MRE-Prävalenz Deutschland MRSA ESBL Prävalenz in der Allgemeinbevölkerung 1,6-3,1% 1 6,3% (E. coli) 2 Prävalenz in Pflegeheim-Bewohnern
ESBL in Altenheimen: Ergebnisse einer LGL-Studie Dr. Giuseppe Valenza MRE-Prävalenz Deutschland MRSA ESBL Prävalenz in der Allgemeinbevölkerung 1,6-3,1% 1 6,3% (E. coli) 2 Prävalenz in Pflegeheim-Bewohnern
NACHWEIS von FEUERBRAND an PFLANZENPROBEN im LABOR
 NACHWEIS von FEUERBRAND an PFLANZENPROBEN im LABOR Mag. Helga Reisenzein Abteilung Phytopathologie in Raumkulturen Institut für Pflanzengesundheit Wien, Juni 2010 www.ages.at Österreichische Agentur für
NACHWEIS von FEUERBRAND an PFLANZENPROBEN im LABOR Mag. Helga Reisenzein Abteilung Phytopathologie in Raumkulturen Institut für Pflanzengesundheit Wien, Juni 2010 www.ages.at Österreichische Agentur für
Schadursachen. Pathogene. Viroide Viren Bakterien Phytoplasmen RLO Pilze parasitische Pflanzen. Nematoden Schnecken Milben Insekten Vögel Säuger
 Schadursachen Pathogene Viroide Viren Bakterien Phytoplasmen RLO Pilze parasitische Pflanzen Unkräuter Schadtiere Nematoden Schnecken Milben Insekten Vögel Säuger Merkmale kleinstes Pathogen nur ringförmige,
Schadursachen Pathogene Viroide Viren Bakterien Phytoplasmen RLO Pilze parasitische Pflanzen Unkräuter Schadtiere Nematoden Schnecken Milben Insekten Vögel Säuger Merkmale kleinstes Pathogen nur ringförmige,
Blattkrankheiten beim Mais Welche Möglichkeiten bietet die Züchtung? Dr. Susanne Groh, DuPont Pioneer, Forschungs- und Technologiezentrum Eschbach
 AGRONOMY-INFORMATIONEN Blattkrankheiten beim Mais Welche Möglichkeiten bietet die Züchtung? Dr. Susanne Groh, DuPont Pioneer, Forschungs- und Technologiezentrum Eschbach Blattkrankheiten können im Mais
AGRONOMY-INFORMATIONEN Blattkrankheiten beim Mais Welche Möglichkeiten bietet die Züchtung? Dr. Susanne Groh, DuPont Pioneer, Forschungs- und Technologiezentrum Eschbach Blattkrankheiten können im Mais
Feuerbrand - Eine bedrohliche Pflanzenkrankheit
 Feuerbrand - Eine bedrohliche Pflanzenkrankheit 1) Begriffserklärung Erstauftreten Feuerbrand ist eine hochinfektiöse, schwer zu bekämpfende, bakterielle Krankheit und stellt eine ernstzunehmende Gefahr
Feuerbrand - Eine bedrohliche Pflanzenkrankheit 1) Begriffserklärung Erstauftreten Feuerbrand ist eine hochinfektiöse, schwer zu bekämpfende, bakterielle Krankheit und stellt eine ernstzunehmende Gefahr
Forschungsgespräch LFZ Klosterneuburg, 29.11.2013 Übersicht - Projekte Pflanzengesundheit Obstbau
 Forschungsgespräch LFZ Klosterneuburg, 29.11.2013 Übersicht - Projekte Pflanzengesundheit Obstbau Abt. Pflanzengesundheit in Obst-, Wein- und Spezialkulturen & Abt. Molekularbiologische Diagnose von Pflanzenkrankheiten
Forschungsgespräch LFZ Klosterneuburg, 29.11.2013 Übersicht - Projekte Pflanzengesundheit Obstbau Abt. Pflanzengesundheit in Obst-, Wein- und Spezialkulturen & Abt. Molekularbiologische Diagnose von Pflanzenkrankheiten
Gentechnologie für Einsteiger
 T. A. Brown Gentechnologie für Einsteiger 3. Auflage Aus dem Englischen übersetzt von Sebastian Vogel Spektrum Akademischer Verlag Heidelberg Berlin Vorwort Vorwort zur dritten englischen Auflage Vorwort
T. A. Brown Gentechnologie für Einsteiger 3. Auflage Aus dem Englischen übersetzt von Sebastian Vogel Spektrum Akademischer Verlag Heidelberg Berlin Vorwort Vorwort zur dritten englischen Auflage Vorwort
ANGABEN ZUM EMPFÄNGERORGANISMUS 1
 ANGABEN ZUM EMPFÄNGERORGANISMUS 1 I. CHARAKTERISIERUNG DES EMPFÄNGERORGANISMUS 1. Vollständiger Name, taxonomischer Name bei Mikroorganismen sowie Zellkulturen (i.s. von 3 Nr. 1 und 1a GenTSV) Ursprung
ANGABEN ZUM EMPFÄNGERORGANISMUS 1 I. CHARAKTERISIERUNG DES EMPFÄNGERORGANISMUS 1. Vollständiger Name, taxonomischer Name bei Mikroorganismen sowie Zellkulturen (i.s. von 3 Nr. 1 und 1a GenTSV) Ursprung
27 Funktionelle Genomanalysen Sachverzeichnis
 Inhaltsverzeichnis 27 Funktionelle Genomanalysen... 543 27.1 Einleitung... 543 27.2 RNA-Interferenz: sirna/shrna-screens 543 Gunter Meister 27.3 Knock-out-Technologie: homologe Rekombination im Genom der
Inhaltsverzeichnis 27 Funktionelle Genomanalysen... 543 27.1 Einleitung... 543 27.2 RNA-Interferenz: sirna/shrna-screens 543 Gunter Meister 27.3 Knock-out-Technologie: homologe Rekombination im Genom der
FEUERBRAND. - ein alter Bekannter kommt wieder. R. Schmidt, 18. Nordische Baumtage 2008, Rostock
 Landesamt für Landwirtschaft, Lebensmittelsicherheit und Fischerei Pflanzenschutzdienst FEUERBRAND - ein alter Bekannter kommt wieder R. Schmidt, 18. Nordische Baumtage 2008, Rostock Erreger Bakterium
Landesamt für Landwirtschaft, Lebensmittelsicherheit und Fischerei Pflanzenschutzdienst FEUERBRAND - ein alter Bekannter kommt wieder R. Schmidt, 18. Nordische Baumtage 2008, Rostock Erreger Bakterium
Auswertung der Surveillance von darmpathogener Escherichia coli Hélène Englund
 Auswertung der Surveillance von darmpathogener Escherichia coli Hélène Englund [email protected] Hintergrund Escherichia coli Teil der normalen humanen Darmflora Stämme mit Virulenzfaktoren können
Auswertung der Surveillance von darmpathogener Escherichia coli Hélène Englund [email protected] Hintergrund Escherichia coli Teil der normalen humanen Darmflora Stämme mit Virulenzfaktoren können
Schriftenreihe Lebensmitteichemische Gesellschaft - Band 27. Neue EU-Regelungen für gentechnisch veränderte Lebensmittel und Futtermittel
 Schriftenreihe Lebensmitteichemische Gesellschaft - Band 27 Neue EU-Regelungen für gentechnisch veränderte Lebensmittel und Futtermittel Aspekte zur Umsetzung in die Praxis - Recht, Überwachung, Probenahme,
Schriftenreihe Lebensmitteichemische Gesellschaft - Band 27 Neue EU-Regelungen für gentechnisch veränderte Lebensmittel und Futtermittel Aspekte zur Umsetzung in die Praxis - Recht, Überwachung, Probenahme,
Horizontaler Gentransfer. Referentin: Michaela Baune Seminar: Gentechnik in der Landwirtschaft
 Horizontaler Gentransfer Referentin: Michaela Baune Seminar: Gentechnik in der Landwirtschaft 28.06.2016 2 Einleitung Abb. 1 3 Einleitung Befürchtung: Übertragung von Antibiotikaresistenzen von transgenen
Horizontaler Gentransfer Referentin: Michaela Baune Seminar: Gentechnik in der Landwirtschaft 28.06.2016 2 Einleitung Abb. 1 3 Einleitung Befürchtung: Übertragung von Antibiotikaresistenzen von transgenen
TB , 1865, 1943 TB
 TB 1 Ordnen Sie die Jahreszahlen den Entdeckungen zu: 1882, 1865, 1943 TB ist ansteckend Entdeckung von Drogen, die den TB Erreger töten Entdeckung des TB Erregers TB 2 Welche(r) dieser Organismen verursacht
TB 1 Ordnen Sie die Jahreszahlen den Entdeckungen zu: 1882, 1865, 1943 TB ist ansteckend Entdeckung von Drogen, die den TB Erreger töten Entdeckung des TB Erregers TB 2 Welche(r) dieser Organismen verursacht
Genotyping Platform der Abteilung Wein- und Obstbau der BOKU
 Genotyping Platform der Abteilung Wein- und Obstbau der BOKU Dr. Ulrike CM Anhalt Ulrike CM Anhalt I Abteilung Wein- und Obstbau I BOKU Wien Idee der Plattform Verbindung von Grundlagenforschung und serviceorientierte,
Genotyping Platform der Abteilung Wein- und Obstbau der BOKU Dr. Ulrike CM Anhalt Ulrike CM Anhalt I Abteilung Wein- und Obstbau I BOKU Wien Idee der Plattform Verbindung von Grundlagenforschung und serviceorientierte,
Die Echtheit sächsischer Wildbirnenbestände Morphologische und genetische Betrachtungen
 Die Echtheit sächsischer Wildbirnenbestände Morphologische und genetische Betrachtungen Frank Lochschmidt und Dr. Stefanie Reim Grüne Liga Osterzgebirge e.v. + Staatsbetrieb Sachsenforst Zinnwald, 18.
Die Echtheit sächsischer Wildbirnenbestände Morphologische und genetische Betrachtungen Frank Lochschmidt und Dr. Stefanie Reim Grüne Liga Osterzgebirge e.v. + Staatsbetrieb Sachsenforst Zinnwald, 18.
1 Einleitung... 1. 2 Material und Methoden... 11. Inhaltsverzeichnis. 1.1 Venturia inaequalis... 3. 1.1.1 Die Biologie des Erregers...
 Inhaltsverzeichnis 1 Einleitung... 1 1.1 Venturia inaequalis... 3 1.1.1 Die Biologie des Erregers... 3 1.1.2 Symptome... 4 1.1.3 In vitro-testsysteme für das Pathosystem Malus/V. inaequalis... 6 1.2 Die
Inhaltsverzeichnis 1 Einleitung... 1 1.1 Venturia inaequalis... 3 1.1.1 Die Biologie des Erregers... 3 1.1.2 Symptome... 4 1.1.3 In vitro-testsysteme für das Pathosystem Malus/V. inaequalis... 6 1.2 Die
Inhaltsverzeichnis... I. Ein Vorwort... VII. Synopse der Arbeit... IX. Synopsis of the thesis... XIII
 I INHALTSVERZEICHNIS Inhaltsverzeichnis... I Ein Vorwort... VII Synopse der Arbeit... IX Synopsis of the thesis... XIII A. Untersuchungen über die Stereoselektivität bakterieller, Pyruvat-abhängiger Aldolasen...
I INHALTSVERZEICHNIS Inhaltsverzeichnis... I Ein Vorwort... VII Synopse der Arbeit... IX Synopsis of the thesis... XIII A. Untersuchungen über die Stereoselektivität bakterieller, Pyruvat-abhängiger Aldolasen...
Erlensterben durch Phytophthora an Fließgewässern
 Einleitung Seit rund zehn Jahren werden in verschiedenen Ländern Europas zunehmend Erkrankungen von Erlen beobachtet, die durch pilzähnliche Mikroorganismen ausgelöst werden. Diese Mikroorganismen (Phytophthora
Einleitung Seit rund zehn Jahren werden in verschiedenen Ländern Europas zunehmend Erkrankungen von Erlen beobachtet, die durch pilzähnliche Mikroorganismen ausgelöst werden. Diese Mikroorganismen (Phytophthora
Feuerbrand ein aktuelles Thema oder Schnee von gestern?
 Feuerbrand ein aktuelles Thema oder Schnee von gestern? 22. August 2015 U. Persen, [email protected] www.ages.at Österreichische Agentur für Gesundheit und Ernährungssicherheit GmbH www.ages.at 2 3
Feuerbrand ein aktuelles Thema oder Schnee von gestern? 22. August 2015 U. Persen, [email protected] www.ages.at Österreichische Agentur für Gesundheit und Ernährungssicherheit GmbH www.ages.at 2 3
Antibiotikaresistenz: Carbapenemase-bildende Keime in Nutztierbeständen
Antibiotikaresistenz: Carbapenemase-bildende Keime in Nutztierbeständen Aktualisierte Mitteilung Nr. 036/2016 des BfR vom 23.12.2016* Carbapeneme sind Antibiotika, die für die Behandlung von Menschen zugelassen
Antibiotikaresistenz: Carbapenemase-bildende Keime in Nutztierbeständen Aktualisierte Mitteilung Nr. 036/2016 des BfR vom 23.12.2016* Carbapeneme sind Antibiotika, die für die Behandlung von Menschen zugelassen
Feuerbrand ein aktuelles Thema oder Schnee von gestern?
 Feuerbrand ein aktuelles Thema oder Schnee von gestern? DI Ulrike Persen [email protected] Institut für Nachhaltige Pflanzenproduktion Int. Streuobstkongress Birnenleben Zeillern, 22.08.2015 Österreichische
Feuerbrand ein aktuelles Thema oder Schnee von gestern? DI Ulrike Persen [email protected] Institut für Nachhaltige Pflanzenproduktion Int. Streuobstkongress Birnenleben Zeillern, 22.08.2015 Österreichische
Entwicklung und Anwendung von Methoden zur Differenzierung von Funktionen und Strukturen bakterieller Populationen des Bodens
 6 Entwicklung und Anwendung von Methoden zur Differenzierung von Funktionen und Strukturen bakterieller Populationen des Bodens Von der Gemeinsamen Naturwissenschaftlichen Fakultät der Technischen Universität
6 Entwicklung und Anwendung von Methoden zur Differenzierung von Funktionen und Strukturen bakterieller Populationen des Bodens Von der Gemeinsamen Naturwissenschaftlichen Fakultät der Technischen Universität
Wie ist das Wuchs- und Ertragsverhalten von neuen, schwachwachsenden M 9-Klonen bei den Sorten `Rubinette`und `Jonagold, 2381 (Nicobel)`zu beurteilen?
 Wie ist das Wuchs- und Ertragsverhalten von neuen, schwachwachsenden M 9-Klonen bei den Sorten ``und `Jonagold, 2381 (Nicobel)`zu beurteilen? Im Dezember 1992 wurde ein Leistungsvergleich von verschiedenen
Wie ist das Wuchs- und Ertragsverhalten von neuen, schwachwachsenden M 9-Klonen bei den Sorten ``und `Jonagold, 2381 (Nicobel)`zu beurteilen? Im Dezember 1992 wurde ein Leistungsvergleich von verschiedenen
rmedizinisch elevante Serologie er Lyme-Borreliose n Europa: erzeitiger Stand, robleme und Ausblick eterinärmedizinisch
 eterinärmedizinisch rmedizinisch elevante Serologie er Lyme-Borreliose n Europa: erzeitiger Stand, robleme und Ausblick Veterinärmedizinische Fakultät Institut für Immunologie Biotechnologisch-Biomedizinisches
eterinärmedizinisch rmedizinisch elevante Serologie er Lyme-Borreliose n Europa: erzeitiger Stand, robleme und Ausblick Veterinärmedizinische Fakultät Institut für Immunologie Biotechnologisch-Biomedizinisches
Leitfaden zur Beprobung von Fischbeständen zum Nachweis von Koi-Herpesviren (KHV)
 # $ $! "! Leitfaden zur Beprobung von Fischbeständen zum Nachweis von Koi-Herpesviren (KHV) Aus fachlicher Sicht können zum Thema KHV zum jetzigen Zeitpunkt (Februar 2007) folgende Empfehlungen gegeben
# $ $! "! Leitfaden zur Beprobung von Fischbeständen zum Nachweis von Koi-Herpesviren (KHV) Aus fachlicher Sicht können zum Thema KHV zum jetzigen Zeitpunkt (Februar 2007) folgende Empfehlungen gegeben
Gentechnik ist weder gut noch böse. Sie gibt uns neue
 VERSUCHUNG GENTECHNIK? Sobald ihr davon esst, gehen euch die Augen auf; ihr werdet wie Gott und erkennt Gut und Böse. (Gen/1. Mose 3,5) Gentechnik ist weder gut noch böse. Sie gibt uns neue Methoden, mit
VERSUCHUNG GENTECHNIK? Sobald ihr davon esst, gehen euch die Augen auf; ihr werdet wie Gott und erkennt Gut und Böse. (Gen/1. Mose 3,5) Gentechnik ist weder gut noch böse. Sie gibt uns neue Methoden, mit
Fortschritte in der Diagnostik häufiger Infektionskrankheiten. Ursula Flückiger Zentrum Innere Medizin Hirslanden Klinik Aarau
 Fortschritte in der Diagnostik häufiger Infektionskrankheiten Ursula Flückiger Zentrum Innere Medizin Hirslanden Klinik Aarau Themen Maldi TOF: Identifikation von Bakterien Durchfall, Pneumonie Mulitplex
Fortschritte in der Diagnostik häufiger Infektionskrankheiten Ursula Flückiger Zentrum Innere Medizin Hirslanden Klinik Aarau Themen Maldi TOF: Identifikation von Bakterien Durchfall, Pneumonie Mulitplex
Inhalt. Entdeckung und allgemeine Informationen. Klassifizierung. Genom Viren untypische Gene Tyrosyl-tRNA Synthetase. Ursprung von grossen DNA Viren
 Mimivirus Inhalt Entdeckung und allgemeine Informationen Klassifizierung Genom Viren untypische Gene Tyrosyl-tRNA Synthetase Ursprung von grossen DNA Viren Entstehung von Eukaryoten Entdeckung 1992 in
Mimivirus Inhalt Entdeckung und allgemeine Informationen Klassifizierung Genom Viren untypische Gene Tyrosyl-tRNA Synthetase Ursprung von grossen DNA Viren Entstehung von Eukaryoten Entdeckung 1992 in
Tuberkulose: Krankheit und Behandlung
 Tuberkulose: Krankheit und Behandlung Dr. Siegfried Throm, vfa Die Infektionskrankheit Tuberkulose (TB) Erreger: Übertragung: Mykobakterien (Mycobacterium tuberculosis) durch Tröpfcheninfektion, Einatmen
Tuberkulose: Krankheit und Behandlung Dr. Siegfried Throm, vfa Die Infektionskrankheit Tuberkulose (TB) Erreger: Übertragung: Mykobakterien (Mycobacterium tuberculosis) durch Tröpfcheninfektion, Einatmen
MODULE für den SCHULKOFFER GENTECHNIK
 MODULE für den SCHULKOFFER GENTECHNIK Modul 1 - DNA-Bastel-Set Zusammenbau eines Papiermodells in Form einer Doppelhelix sehr einfach, Unterstufe, ohne Koffer möglich Modul 2 - DNA-Isolierung aus Gemüse
MODULE für den SCHULKOFFER GENTECHNIK Modul 1 - DNA-Bastel-Set Zusammenbau eines Papiermodells in Form einer Doppelhelix sehr einfach, Unterstufe, ohne Koffer möglich Modul 2 - DNA-Isolierung aus Gemüse
Blattsaugerdichten und Auswirkungen auf den Apfeltriebsuchtbefall 9 Jahre Versuche zur Bekämpfung der Blattsauger
 Blattsaugerdichten und Auswirkungen auf den Apfeltriebsuchtbefall 9 Jahre Versuche zur Bekämpfung der Blattsauger Werner Rizzolli, Alex Acler, Versuchszentrum Laimburg Die Apfeltriebsucht (AP) ist eine
Blattsaugerdichten und Auswirkungen auf den Apfeltriebsuchtbefall 9 Jahre Versuche zur Bekämpfung der Blattsauger Werner Rizzolli, Alex Acler, Versuchszentrum Laimburg Die Apfeltriebsucht (AP) ist eine
Urogenitale Infektionserreger mittels PCR
 Urogenitale Infektionserreger mittels PCR Dr. Monika Börner Planegg 09. September 2009 Urogenitale Infektionserreger mittels PCR Grundlagen / Allgemeines Chlamydia trachomatis Neisseria gonorrhoeae Mykoplasmen
Urogenitale Infektionserreger mittels PCR Dr. Monika Börner Planegg 09. September 2009 Urogenitale Infektionserreger mittels PCR Grundlagen / Allgemeines Chlamydia trachomatis Neisseria gonorrhoeae Mykoplasmen
Gezielt ist besser! Optimierung von Diagnostik verbessert die Therapie von Lungeninfektionen
 Optimierung von Diagnostik verbessert die Therapie von Lungeninfektionen Herr Dr. med. Marcus Berkefeld Frau Dr. med. Ilka Engelmann Klassische Methoden des Virusnachweis 1. direkter Immun-Fluoreszenz-Test
Optimierung von Diagnostik verbessert die Therapie von Lungeninfektionen Herr Dr. med. Marcus Berkefeld Frau Dr. med. Ilka Engelmann Klassische Methoden des Virusnachweis 1. direkter Immun-Fluoreszenz-Test
Tollwut Fakten und Vorsichtsmaßnahmen
 Tollwut Fakten und Vorsichtsmaßnahmen 2 Was ist Tollwut? Tollwut ist eine lebensbedrohliche Virusinfektion, die bei Tieren und Menschen eine akute Gehirnhautentzündung verursacht. Die Tollwut kann überall
Tollwut Fakten und Vorsichtsmaßnahmen 2 Was ist Tollwut? Tollwut ist eine lebensbedrohliche Virusinfektion, die bei Tieren und Menschen eine akute Gehirnhautentzündung verursacht. Die Tollwut kann überall
Mikrobiologisches Grundpraktikum: Ein Farbatlas
 Steve K. Alexander / Dennis Strete Mikrobiologisches Grundpraktikum: Ein Farbatlas Deutsche Bearbeitung von Erika Kothe Aus dem Amerikanischen von Hans W. Kothe und Erika Kothe Ein Imprint von Pearson
Steve K. Alexander / Dennis Strete Mikrobiologisches Grundpraktikum: Ein Farbatlas Deutsche Bearbeitung von Erika Kothe Aus dem Amerikanischen von Hans W. Kothe und Erika Kothe Ein Imprint von Pearson
Schwarzholz - Eine sich ausbreitende Krankheit im Südtiroler Weinbau
 Schwarzholz - Eine sich ausbreitende Krankheit im Südtiroler Weinbau In zahlreichen Rebanlagen konnten in den letzten Jahren Rebstöcke mit auffälligen nach unten eingedrehten Blatträndern, roten oder gelben
Schwarzholz - Eine sich ausbreitende Krankheit im Südtiroler Weinbau In zahlreichen Rebanlagen konnten in den letzten Jahren Rebstöcke mit auffälligen nach unten eingedrehten Blatträndern, roten oder gelben
Sexuell übertragbare Infektionen MUSTER. Sexuell übertragbare. Was muss ich wissen?
 Sexuell übertragbare Infektionen Sexuell übertragbare Infektionen Was muss ich wissen? Was sind STDs? Sexuell übertragbare Infektionen (STD sexually transmitted diseases) werden durch verschiedene Erreger
Sexuell übertragbare Infektionen Sexuell übertragbare Infektionen Was muss ich wissen? Was sind STDs? Sexuell übertragbare Infektionen (STD sexually transmitted diseases) werden durch verschiedene Erreger
Diagnostik von Infektionen. Professor Christian Ruef Institut für Infektiologie und Spitalhygiene
 Diagnostik von Infektionen Professor Christian Ruef Institut für Infektiologie und Spitalhygiene 1 Schwerpunkte Einleitung, Uebersicht Klinische Beispiele Sepsis Pneumonie auf der Intensivstation Ausblick
Diagnostik von Infektionen Professor Christian Ruef Institut für Infektiologie und Spitalhygiene 1 Schwerpunkte Einleitung, Uebersicht Klinische Beispiele Sepsis Pneumonie auf der Intensivstation Ausblick
Synthetische Biologie
 Synthetische Biologie Segen oder Fluch? http://www.kwick.de Science Bridge - SG 19.11.2010 1 Gliederung 2 Was ist Synthetische Biologie? Fortschritt und Potential der synthetischen Biologie Ethische Aspekte
Synthetische Biologie Segen oder Fluch? http://www.kwick.de Science Bridge - SG 19.11.2010 1 Gliederung 2 Was ist Synthetische Biologie? Fortschritt und Potential der synthetischen Biologie Ethische Aspekte
Nachweis von Viren in Obstgehölzen
 Nachweis von Viren in Obstgehölzen In vielen Kleingärten werden immer wieder hitzige Diskussionen über das mangelnde Wachstum von Obstgehölzen geführt. Dabei wird über Nachbauprobleme geredet, über schlechte
Nachweis von Viren in Obstgehölzen In vielen Kleingärten werden immer wieder hitzige Diskussionen über das mangelnde Wachstum von Obstgehölzen geführt. Dabei wird über Nachbauprobleme geredet, über schlechte
Projektskizze: Studie/ Auswertung/ Publikation
 Projektskizze: Studie/ Auswertung/ Publikation Name: PD Dr. Dr. Robert Bals, CAPNetz C11 Datum: 30. 8. 2007 Institution(en)/Autor(en): Klinikum der Universität Marburg Klinik für Innere Medizin mit Schwerpunkt
Projektskizze: Studie/ Auswertung/ Publikation Name: PD Dr. Dr. Robert Bals, CAPNetz C11 Datum: 30. 8. 2007 Institution(en)/Autor(en): Klinikum der Universität Marburg Klinik für Innere Medizin mit Schwerpunkt
Neues Triebsterben an Buxus - nun auch in Mecklenburg-Vorpommern -
 Landesamt für Landwirtschaft, Lebensmittelsicherheit und Fischerei Pflanzenschutzdienst Neues Triebsterben an Buxus - nun auch in Mecklenburg-Vorpommern - Erreger/ Historie Symptome Biologie Vorbeugung/
Landesamt für Landwirtschaft, Lebensmittelsicherheit und Fischerei Pflanzenschutzdienst Neues Triebsterben an Buxus - nun auch in Mecklenburg-Vorpommern - Erreger/ Historie Symptome Biologie Vorbeugung/
GENTECHNIK BEI PFLANZEN
 - 1 - GENTECHNIK BEI PFLANZEN 1. Grüne Gentechnik - was ist das? "Grüne Gentechnik" ist laut Gentechnik-Wörterbuch eine "umgangssprachliche Bezeichnung für gentechnische Forschung mit Pflanzen, während
- 1 - GENTECHNIK BEI PFLANZEN 1. Grüne Gentechnik - was ist das? "Grüne Gentechnik" ist laut Gentechnik-Wörterbuch eine "umgangssprachliche Bezeichnung für gentechnische Forschung mit Pflanzen, während
Die neue Druckgeräterichtlinie 2014/68/EU
 Die neue Druckgeräterichtlinie 2014/68/EU Winfried Schock Leiter der Benannten Stelle für Druckgeräte der TÜV SÜD Industrie Service GmbH Mitteldeutsche Druckgerätetage Merseburg, 10.11.2016 Folie 1 Neue
Die neue Druckgeräterichtlinie 2014/68/EU Winfried Schock Leiter der Benannten Stelle für Druckgeräte der TÜV SÜD Industrie Service GmbH Mitteldeutsche Druckgerätetage Merseburg, 10.11.2016 Folie 1 Neue
Die Diagnostik der Koi-Herpesvirus-Infektion
 Die Diagnostik der Koi-Herpesvirus-Infektion Sven M. Bergmann und Dieter Fichtner Institut für Infektionsmedizin Nationales Referenzlabor für Fischkrankheiten Verbreitung der Infektion mit dem KHV Klinisches
Die Diagnostik der Koi-Herpesvirus-Infektion Sven M. Bergmann und Dieter Fichtner Institut für Infektionsmedizin Nationales Referenzlabor für Fischkrankheiten Verbreitung der Infektion mit dem KHV Klinisches
Module der AG Molekulare Zoologie für Biologie
 Wissenschaftszentrum Weihenstephan für Ernährung, Landnutzung und Umwelt Module der AG Molekulare Zoologie für Biologie Modulname ECTS Lehrveranstaltung Sem Dozent Evolution, Biodiversität und Biogeographie
Wissenschaftszentrum Weihenstephan für Ernährung, Landnutzung und Umwelt Module der AG Molekulare Zoologie für Biologie Modulname ECTS Lehrveranstaltung Sem Dozent Evolution, Biodiversität und Biogeographie
Evolution II. Molekulare Variabilität. Bachelorkurs Evolutionsbiolgie II WS 2013/14
 Evolution II Molekulare Variabilität Bachelorkurs Evolutionsbiolgie II WS 2013/14 Molekulare Variabilität 1) rten der molekularen Variabilität und ihre Entstehung (rten der Mutation) 2) Wie kann man molekulare
Evolution II Molekulare Variabilität Bachelorkurs Evolutionsbiolgie II WS 2013/14 Molekulare Variabilität 1) rten der molekularen Variabilität und ihre Entstehung (rten der Mutation) 2) Wie kann man molekulare
Prävalenz bei ambulanten Patienten mit ambulant erworbener Pneumonie nach Erreger
 Produktnummer: IF1250M Rev. I Leistungsmerkmale Nicht für den Vertrieb in den USA ERWARTETE WERTE Patienten mit ambulant erworbener Pneumonie Zwei externe Prüfer untersuchten den Focus Chlamydia MIF IgM
Produktnummer: IF1250M Rev. I Leistungsmerkmale Nicht für den Vertrieb in den USA ERWARTETE WERTE Patienten mit ambulant erworbener Pneumonie Zwei externe Prüfer untersuchten den Focus Chlamydia MIF IgM
Virale Infektionen Infektionsmuster. Zellbiologische Definitionen
 Virale Infektionen Zellbiologische Definitionen 1. Infektion: Eintritt eines Replikations-fähigen viralen Genoms in die Zelle. Die Infektion kann aber muss nicht zur Vermehrung des Virus führen. Epitheliale
Virale Infektionen Zellbiologische Definitionen 1. Infektion: Eintritt eines Replikations-fähigen viralen Genoms in die Zelle. Die Infektion kann aber muss nicht zur Vermehrung des Virus führen. Epitheliale
Stand der Erkenntnisse zum Auftreten der Apfeltriebsucht im Südtiroler Obstbau Manfred Wolf, Versuchszentrum Laimburg
 Stand der Erkenntnisse zum Auftreten der Apfeltriebsucht im Südtiroler Obstbau Manfred Wolf, Versuchszentrum Laimburg Seit dem Beginn der ersten Ausbreitung der Apfeltriebsucht im Südtiroler Erwerbsobstbau
Stand der Erkenntnisse zum Auftreten der Apfeltriebsucht im Südtiroler Obstbau Manfred Wolf, Versuchszentrum Laimburg Seit dem Beginn der ersten Ausbreitung der Apfeltriebsucht im Südtiroler Erwerbsobstbau
Präventives Tigermücken-Monitoringan Hauptverkehrsadern Südhessens
 Präventives Tigermücken-Monitoringan Hauptverkehrsadern Südhessens Monitoring, Identifikation und Prävention invasiver Krankheitsüberträger Ulrich Kuch Emerging and Neglected Tropical Diseases Unit Biodiversity
Präventives Tigermücken-Monitoringan Hauptverkehrsadern Südhessens Monitoring, Identifikation und Prävention invasiver Krankheitsüberträger Ulrich Kuch Emerging and Neglected Tropical Diseases Unit Biodiversity
Saatgut und Lebensmittel: Zunehmende Monopolisierung durch Patente und Marktkonzentration.
 Saatgut und Lebensmittel: Zunehmende Monopolisierung durch Patente und Marktkonzentration www.no-patents-on-seeds.org Marktkonzentration: Zehn Unternehmen kontrollieren etwa 2/3 des globalen Saatgutmarktes
Saatgut und Lebensmittel: Zunehmende Monopolisierung durch Patente und Marktkonzentration www.no-patents-on-seeds.org Marktkonzentration: Zehn Unternehmen kontrollieren etwa 2/3 des globalen Saatgutmarktes
Biochemie. Arbeitsgruppen. AG Frederik Börnke. AG Jörg Hofmann. AG Christian Koch. AG Uwe Sonnewald. AG Sophia Sonnewald.
 Biochemie Arbeitsgruppen AG Frederik Börnke AG Jörg Hofmann AG Christian Koch AG Uwe Sonnewald AG Sophia Sonnewald AG Lars Voll http://www.biologie.uni-erlangen.de/bc/bchome.html Biochemie Forschungsprogramme
Biochemie Arbeitsgruppen AG Frederik Börnke AG Jörg Hofmann AG Christian Koch AG Uwe Sonnewald AG Sophia Sonnewald AG Lars Voll http://www.biologie.uni-erlangen.de/bc/bchome.html Biochemie Forschungsprogramme
Sexuelle Übertragbarkeit von Borrelien- Erste Ergebnisse der Studie mit der Universität Jyväskylä, Finnland
 Sexuelle Übertragbarkeit von Borrelien- Erste Ergebnisse der Studie mit der Universität Jyväskylä, Finnland Ärztliche Fortbildung Augsburg, 27.2.2016 Dr. H.G.Maxeiner, BCA-lab, Augsburg, Germany Literatur
Sexuelle Übertragbarkeit von Borrelien- Erste Ergebnisse der Studie mit der Universität Jyväskylä, Finnland Ärztliche Fortbildung Augsburg, 27.2.2016 Dr. H.G.Maxeiner, BCA-lab, Augsburg, Germany Literatur
Grüne Gentechnik. Parlamentarischer Abend der Deutschen Forschungsgemeinschaft am 22. März 2010 in Berlin
 Grüne Gentechnik Parlamentarischer Abend der Deutschen Forschungsgemeinschaft am 22. März 2010 in Berlin Was bringt die Grüne Gentechnik in der Pflanzenzüchtung? Christian Jung, Universität Kiel Die Entwicklung
Grüne Gentechnik Parlamentarischer Abend der Deutschen Forschungsgemeinschaft am 22. März 2010 in Berlin Was bringt die Grüne Gentechnik in der Pflanzenzüchtung? Christian Jung, Universität Kiel Die Entwicklung
Mathematik EP - Stochastik VIERFELDERTAFEL UND BEDINGTE WKT.
 Mathematik EP - Stochastik VIERFELDERTAFEL UND BEDINGTE WKT. HIV - SCHNELLTEST Die Immunschwächekrankheit AIDS wird durch das HI-Virus, welches 1993 entdeckt wurde, verursacht. Die Krankheit gilt bis heute
Mathematik EP - Stochastik VIERFELDERTAFEL UND BEDINGTE WKT. HIV - SCHNELLTEST Die Immunschwächekrankheit AIDS wird durch das HI-Virus, welches 1993 entdeckt wurde, verursacht. Die Krankheit gilt bis heute
Vereinbarkeit von Familie und Beruf in Europa
 Melanie Kupsch Vereinbarkeit von Familie und Beruf in Europa Auswirkungen beruflicher und familiärer Stressoren und Ressourcen in Doppelverdienerhaushalten mit jungen Kindern auf die Konfliktübertragung
Melanie Kupsch Vereinbarkeit von Familie und Beruf in Europa Auswirkungen beruflicher und familiärer Stressoren und Ressourcen in Doppelverdienerhaushalten mit jungen Kindern auf die Konfliktübertragung
Verbreitung von Insektizidresistenzen in Thüringen
 Verbreitung von Insektizidresistenzen in Thüringen, Thüringer Landesanstalt für Landwirtschaft 24. Thüringer Düngungs-und Pflanzenschutztagung Erfurt, den 19.11.2015 Gliederung 1. Allgemeines zu Resistenzen
Verbreitung von Insektizidresistenzen in Thüringen, Thüringer Landesanstalt für Landwirtschaft 24. Thüringer Düngungs-und Pflanzenschutztagung Erfurt, den 19.11.2015 Gliederung 1. Allgemeines zu Resistenzen
AGES-Webribo. Systematik in Clostridium difficile PCR-Ribotyping. Alexander Indra
 AGES-Webribo Systematik in Clostridium difficile PCR-Ribotyping Alexander Indra AGES-Institut für medizinische Mikrobiologie und Hygiene Wien Nationale Referenzzentrale für Clostridium difficile Clostridium
AGES-Webribo Systematik in Clostridium difficile PCR-Ribotyping Alexander Indra AGES-Institut für medizinische Mikrobiologie und Hygiene Wien Nationale Referenzzentrale für Clostridium difficile Clostridium
Kleiner Beutenkäfer. Gekommen um zu bleiben?
 Kleiner Beutenkäfer Gekommen um zu bleiben? 1 Kleiner Beutenkäfer Aufbau 1. Aktuelle Situation 2. Aussehen 3. Lebenszyklus 4. Schäden 5. Bekämpfung 6. Verhalten der Imkerinnen und Imker 2 Verbreitungsgebiete
Kleiner Beutenkäfer Gekommen um zu bleiben? 1 Kleiner Beutenkäfer Aufbau 1. Aktuelle Situation 2. Aussehen 3. Lebenszyklus 4. Schäden 5. Bekämpfung 6. Verhalten der Imkerinnen und Imker 2 Verbreitungsgebiete
Nachweis bakterieller Kontaminationen in Thrombozytenkonzentraten
 Nachweis bakterieller Kontaminationen in Thrombozytenkonzentraten mit der BactiFlow- Durchflusszytometrie: Ergebnisse einer multizentrischen Studie und eines Ringversuches KOLT, Langen, 10.-11. Mai 2011
Nachweis bakterieller Kontaminationen in Thrombozytenkonzentraten mit der BactiFlow- Durchflusszytometrie: Ergebnisse einer multizentrischen Studie und eines Ringversuches KOLT, Langen, 10.-11. Mai 2011
Seminar zur Grundvorlesung Genetik
 Seminar zur Grundvorlesung Genetik Wann? Gruppe B1: Montags, 1600-1700 Wo? Kurt-Mothes-Saal, Leibniz-Institut für Pflanzenbiochemie Teilnahme obligatorisch, max. 1x abwesend Kontaktdaten Marcel Quint Leibniz-Institut
Seminar zur Grundvorlesung Genetik Wann? Gruppe B1: Montags, 1600-1700 Wo? Kurt-Mothes-Saal, Leibniz-Institut für Pflanzenbiochemie Teilnahme obligatorisch, max. 1x abwesend Kontaktdaten Marcel Quint Leibniz-Institut
MERKBLÄTTER DER FORSTLICHEN VERSUCHS- UND FORSCHUNGSANSTALT BADEN-WÜRTTEMBERG (Aus der Abteilung Waldschutz) 1989 Nr. 40
 MERKBLÄTTER DER FORSTLICHEN VERSUCHS- UND FORSCHUNGSANSTALT BADEN-WÜRTTEMBERG (Aus der Abteilung Waldschutz) 1989 Nr. 40 Laubbaumvirosen von F. Nienhaus, Bonn Laubbaumvirosen von F. Nienhaus, Bonn 1 Allgemeines
MERKBLÄTTER DER FORSTLICHEN VERSUCHS- UND FORSCHUNGSANSTALT BADEN-WÜRTTEMBERG (Aus der Abteilung Waldschutz) 1989 Nr. 40 Laubbaumvirosen von F. Nienhaus, Bonn Laubbaumvirosen von F. Nienhaus, Bonn 1 Allgemeines
Die neue Variante der Viruserkrankung RHD
 Die neue Variante der Viruserkrankung RHD Die neue Variante der Viruserkrankung RHD Was ist RHDV-2? Wo ist die Erkrankung bisher aufgetreten? Wie äußert sich die Erkrankung? Weitere wichtige Fakten Wie
Die neue Variante der Viruserkrankung RHD Die neue Variante der Viruserkrankung RHD Was ist RHDV-2? Wo ist die Erkrankung bisher aufgetreten? Wie äußert sich die Erkrankung? Weitere wichtige Fakten Wie
Viren, eine spät sichtbare Gefahr für unsere Bienen
 Viren, eine spät sichtbare Gefahr für unsere Bienen Freitag, 19. April 2013 Aula Landwirtschaftliches Zentrum Ebenrain Sissach Leiter Was sind Viren? Viren sind infektiöse Partikel, die sich ausserhalb
Viren, eine spät sichtbare Gefahr für unsere Bienen Freitag, 19. April 2013 Aula Landwirtschaftliches Zentrum Ebenrain Sissach Leiter Was sind Viren? Viren sind infektiöse Partikel, die sich ausserhalb
voja Projekt ausgewogene Ernährung und ausreichend Bewegung
 1 voja Projekt ausgewogene Ernährung und ausreichend Bewegung Wie kommt die voja dazu ein Projekt zu Ernährung und Bewegung zu machen? Wieso sollte das Thema Ernährung und Bewegung nun für die OKJA relevant
1 voja Projekt ausgewogene Ernährung und ausreichend Bewegung Wie kommt die voja dazu ein Projekt zu Ernährung und Bewegung zu machen? Wieso sollte das Thema Ernährung und Bewegung nun für die OKJA relevant
Besonderheiten der pflanzengesundheitlichen Überwachung in Berlin
 Besonderheiten der pflanzengesundheitlichen Überwachung in Berlin und die Notwendigkeit von Alternativen zum destructive sampling Heiko Schmalstieg, Elke Wedell, Thomas Gerlach Pflanzenschutzamt Berlin
Besonderheiten der pflanzengesundheitlichen Überwachung in Berlin und die Notwendigkeit von Alternativen zum destructive sampling Heiko Schmalstieg, Elke Wedell, Thomas Gerlach Pflanzenschutzamt Berlin
Grundlagen der Phytopathologie
 Institut für Biologie i und Biotechnologie i der Pflanzen Grundlagen der Phytopathologie Paul Tudzynski Grundlagen der Phytopathologie Parasit: ein Organismus, der in enger Assoziation mit einem anderen
Institut für Biologie i und Biotechnologie i der Pflanzen Grundlagen der Phytopathologie Paul Tudzynski Grundlagen der Phytopathologie Parasit: ein Organismus, der in enger Assoziation mit einem anderen
Antibiotikaresistenz bei Nutztieren Übertragungswege zum Menschen
 BUNDESINSTITUT FÜR RISIKOBEWERTUNG Antibiotikaresistenz bei Nutztieren Übertragungswege zum Menschen PD Dr. Bernd-Alois Tenhagen FG Epidemiologie, Zoonosen und Antibiotikaresistenz Worum geht es? Resistenzsituation
BUNDESINSTITUT FÜR RISIKOBEWERTUNG Antibiotikaresistenz bei Nutztieren Übertragungswege zum Menschen PD Dr. Bernd-Alois Tenhagen FG Epidemiologie, Zoonosen und Antibiotikaresistenz Worum geht es? Resistenzsituation
Laufzeit 01.01.2009-31.05.2012 Forschungsstelle
 Entwicklung einer Nachweismethode zur Bewertung von Saatgutchargen bezüglich des prozentualen Befalls von Mycosphaerella anethi an Fenchelfrüchten und Jungpflanzen Laufzeit 01.01.2009-31.05.2012 Forschungsstelle
Entwicklung einer Nachweismethode zur Bewertung von Saatgutchargen bezüglich des prozentualen Befalls von Mycosphaerella anethi an Fenchelfrüchten und Jungpflanzen Laufzeit 01.01.2009-31.05.2012 Forschungsstelle
Die PCR-Diagnostik invasiver Mykosen
 Die PCR-Diagnostik invasiver Mykosen Dr.med. Ralf Bialek Institut für Tropenmedizin, Universitätsklinikum Tübingen Verbreitungsgebiete der Histoplasmose Kultur- und 18S rdna-pcr PCR-Ergebnisse zum
Die PCR-Diagnostik invasiver Mykosen Dr.med. Ralf Bialek Institut für Tropenmedizin, Universitätsklinikum Tübingen Verbreitungsgebiete der Histoplasmose Kultur- und 18S rdna-pcr PCR-Ergebnisse zum
Toleranz gegenüber Staunässe und Überflutung bei Raps
 Projektverbund Strategien zur Anpassung von Kulturpflanzen an den Klimawandel Projektpräsentation Toleranz gegenüber Staunässe und Überflutung bei Raps Angelika Mustroph Universität Bayreuth Lehrstuhl
Projektverbund Strategien zur Anpassung von Kulturpflanzen an den Klimawandel Projektpräsentation Toleranz gegenüber Staunässe und Überflutung bei Raps Angelika Mustroph Universität Bayreuth Lehrstuhl
Inhalt. Erster Teil: Pestizide und biologische Ungleichgewichte
 Inhalt GERHARDT PREUSCHEN Einführung für die deutschsprachigen Leser 11 FRANCIS CHABOUSSOU Vorwort 13 JEAN KEILLING Geleitwort 17 Erster Teil: Pestizide und biologische Ungleichgewichte Kapitel 1 Die Zunahme
Inhalt GERHARDT PREUSCHEN Einführung für die deutschsprachigen Leser 11 FRANCIS CHABOUSSOU Vorwort 13 JEAN KEILLING Geleitwort 17 Erster Teil: Pestizide und biologische Ungleichgewichte Kapitel 1 Die Zunahme
Wurzeleinwuchs in die Infrastruktur urbaner Räume
 Wurzeleinwuchs in die Infrastruktur urbaner Räume Wurzeleinwuchs ein Problem in Städten und Gemeinden Grünpflanzung in urbanen Räumen sorgt für Wohlbefinden und Erholung. Ohne Grünpflanzen und Bäume wären
Wurzeleinwuchs in die Infrastruktur urbaner Räume Wurzeleinwuchs ein Problem in Städten und Gemeinden Grünpflanzung in urbanen Räumen sorgt für Wohlbefinden und Erholung. Ohne Grünpflanzen und Bäume wären
Pflanze direkt 2x PCR-Mastermix
 Datenblatt Artikel-Nr. BS91.322.0250 Artikel-Nr. BS91.322.1250 250 Reaktionen in 20 μl 1250 Reaktionen in 20 μl (Nur für Forschung und in vitro-anwendungen) Chargen-Nr.: Mindestens haltbar bis: Aussehen:
Datenblatt Artikel-Nr. BS91.322.0250 Artikel-Nr. BS91.322.1250 250 Reaktionen in 20 μl 1250 Reaktionen in 20 μl (Nur für Forschung und in vitro-anwendungen) Chargen-Nr.: Mindestens haltbar bis: Aussehen:
Mikrobielle Arten und Taxonomie
 Mikrobielle Arten und Taxonomie - Was ist eine Art? Grundsatz in der Biologie: Kreuzbarkeit, d.h. sexuelle Vermehrung - Bacteria und Archaea vermehren sich asexuell; außerdem horizontaler Gentransfer Hoffnung
Mikrobielle Arten und Taxonomie - Was ist eine Art? Grundsatz in der Biologie: Kreuzbarkeit, d.h. sexuelle Vermehrung - Bacteria und Archaea vermehren sich asexuell; außerdem horizontaler Gentransfer Hoffnung
Getreideroste eine neue Herausforderung
 Getreideroste eine neue Herausforderung Nicole Sommerfeldt-Impe, Bettina Klocke, Kerstin Flath Getreide-Feldtag KWS SAAT, 16.06.2015, Wiebrechtshausen Kerstin Institut Flath für Pflanzenschutz Institut
Getreideroste eine neue Herausforderung Nicole Sommerfeldt-Impe, Bettina Klocke, Kerstin Flath Getreide-Feldtag KWS SAAT, 16.06.2015, Wiebrechtshausen Kerstin Institut Flath für Pflanzenschutz Institut
Listeriose enzephalitische Form bei Schaf und Ziege
 Listeriose enzephalitische Form bei Schaf und Ziege R. Krametter-Frötscher Klinik für Wiederkäuer Veterinärmedizinische Universität Wien Allgemeines bakterielle Infektionskrankheit mit dem gram-positiven
Listeriose enzephalitische Form bei Schaf und Ziege R. Krametter-Frötscher Klinik für Wiederkäuer Veterinärmedizinische Universität Wien Allgemeines bakterielle Infektionskrankheit mit dem gram-positiven
Genetischer Fingerabdruck im Obstbau
 Powered by Seiten-Adresse: Bekannt ist er aus der Kriminalistik oder von Vaterschaftstests - der genetische Fingerabdruck. Dieser findet seinen Einsatz aber auch in der Landwirtschaft. Speziell im Obstbau
Powered by Seiten-Adresse: Bekannt ist er aus der Kriminalistik oder von Vaterschaftstests - der genetische Fingerabdruck. Dieser findet seinen Einsatz aber auch in der Landwirtschaft. Speziell im Obstbau
Transportsysteme in Pflanzen. Alexandra C. U. Furch
 Transportsysteme in Pflanzen Alexandra C. U. Furch Struktur und Funktion der Transportsysteme a. Struktur der Transportsysteme b. Funktionen der Transportsysteme c. Evolution in Landpflanzen d. SE/CC Ontogenese
Transportsysteme in Pflanzen Alexandra C. U. Furch Struktur und Funktion der Transportsysteme a. Struktur der Transportsysteme b. Funktionen der Transportsysteme c. Evolution in Landpflanzen d. SE/CC Ontogenese
Chalara fraxinea einschließlich seiner Teleomorphe Hymenoscyphus pseudoalbidus dürfen nicht in das VK eingeschleppt oder darin verbreitet werden.
 1 GROßBRITANNIEN Die Pflanzengesundheitsverordnung (Forst) (Änderung) 2012 (The Plant Health (Forestry) (Amendment) Order 2012) Quelle: Schreiben der Food and Environment Research Agency vom 29.10.2012
1 GROßBRITANNIEN Die Pflanzengesundheitsverordnung (Forst) (Änderung) 2012 (The Plant Health (Forestry) (Amendment) Order 2012) Quelle: Schreiben der Food and Environment Research Agency vom 29.10.2012
Asiatischer Laubholzbockkäfer
 Asiatischer Laubholzbockkäfer Anoplophora glabripennis Bürgermeisterdienstbesprechung Lkr. München 22.10.2014 Michelangelo Olleck - Dr. Hannes Lemme - Dr. Helmut Tischner Bayerische Landesanstalt für Landwirtschaft
Asiatischer Laubholzbockkäfer Anoplophora glabripennis Bürgermeisterdienstbesprechung Lkr. München 22.10.2014 Michelangelo Olleck - Dr. Hannes Lemme - Dr. Helmut Tischner Bayerische Landesanstalt für Landwirtschaft
Lebensmittel und Gentechnik
 Lebensmittel und Gentechnik Die wichtigsten Fakten www.bmelv.de 1 Gentechnik in Lebensmitteln ist ein sensibles Thema. Nach einer Umfrage im Auftrag des Bundesministeriums für Ernährung, Landwirtschaft
Lebensmittel und Gentechnik Die wichtigsten Fakten www.bmelv.de 1 Gentechnik in Lebensmitteln ist ein sensibles Thema. Nach einer Umfrage im Auftrag des Bundesministeriums für Ernährung, Landwirtschaft
PCR basierte- Detektionstechniken
 PCR basierte- Detektionstechniken Warum überhaupt? Forensische Analysen: Vaterschaftstests, Kriminalistik Mikrobielle Gemeinschaften: Biofilme, medizinische Mikrobiologie 2 Warum überhaupt? minimale Mengen
PCR basierte- Detektionstechniken Warum überhaupt? Forensische Analysen: Vaterschaftstests, Kriminalistik Mikrobielle Gemeinschaften: Biofilme, medizinische Mikrobiologie 2 Warum überhaupt? minimale Mengen
Kleiner Beutenkäfer. Aufbau 1. Aktuelle Situation 2. Aussehen 3. Lebenszyklus 4. Schäden 5. Bekämpfung 6. Verhalten der Imkerinnen und Imker
 Kleiner Beutenkäfer Aufbau 1. Aktuelle Situation 2. Aussehen 3. Lebenszyklus 4. Schäden 5. Bekämpfung 6. Verhalten der Imkerinnen und Imker 1. Aktuelle Situation Der Kleine Beutenkäfer wurde in der Provinz
Kleiner Beutenkäfer Aufbau 1. Aktuelle Situation 2. Aussehen 3. Lebenszyklus 4. Schäden 5. Bekämpfung 6. Verhalten der Imkerinnen und Imker 1. Aktuelle Situation Der Kleine Beutenkäfer wurde in der Provinz
Versuchsbericht 03/2006
 Versuchsbericht 03/2006 zum Entfernen von Blüten in Junganlagen Versuchsverantwortlich: Dr. Thomas Rühmer Versuchsdurchführende: Hannes Ponhold, Ing. Markus Fellner Autor des Berichtes: Versuchsziel: Dr.
Versuchsbericht 03/2006 zum Entfernen von Blüten in Junganlagen Versuchsverantwortlich: Dr. Thomas Rühmer Versuchsdurchführende: Hannes Ponhold, Ing. Markus Fellner Autor des Berichtes: Versuchsziel: Dr.
Infektion und Verbreitung
 Infektion und Verbreitung von epidemiologisch bedeutsamen Erkrankungen Vereinfachtes Schema für Zuständige, Politiker, Verbraucher und allgemein am Thema Interessierte (mit Beispielen zur EHEC-Epidemie
Infektion und Verbreitung von epidemiologisch bedeutsamen Erkrankungen Vereinfachtes Schema für Zuständige, Politiker, Verbraucher und allgemein am Thema Interessierte (mit Beispielen zur EHEC-Epidemie
Thema Gentechnologie. Erwin R. Schmidt Institut für Molekulargenetik Gentechnologische Sicherheitsforschung & Beratung
 Thema Gentechnologie Erwin R. Schmidt Institut für Molekulargenetik Gentechnologische Sicherheitsforschung & Beratung Die Genklonierung in Bakterien Vektor-DNA Spender-DNA Restriktionsenzym Rekombinante
Thema Gentechnologie Erwin R. Schmidt Institut für Molekulargenetik Gentechnologische Sicherheitsforschung & Beratung Die Genklonierung in Bakterien Vektor-DNA Spender-DNA Restriktionsenzym Rekombinante
Vancomycin-resistente Enterokokken ein Problem in Deutschland? Guido Werner, Robert Koch Institut Wernigerode PEG Tagung 2008, Bonn,
 Vancomycinresistente Enterokokken ein Problem in Deutschland? Guido Werner, Robert Koch Institut Wernigerode PEG Tagung 2008, Bonn, 9. 11.10.08 Enterokokken / VRE Intestinale Besiedler in Mensch und Tier
Vancomycinresistente Enterokokken ein Problem in Deutschland? Guido Werner, Robert Koch Institut Wernigerode PEG Tagung 2008, Bonn, 9. 11.10.08 Enterokokken / VRE Intestinale Besiedler in Mensch und Tier
